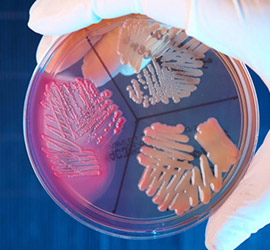

Horario de Atención : Lunes a Sábado de 07:00 am. a 08:30 pm.
atencion@novalabservice.comHorario de Atención : Lunes a Sábado de 07:00 am. a 08:30 pm.
atencion@novalabservice.com
Análisis de laboratorio se le llama comúnmente a la exploración complementaria solicitada al laboratorio clínico por un médico para confirmar o descartar un diagnóstico.
En estos laboratorios clínicos existen las llamadas Areas o Secciones que ayudan al laboratorista a clasificar los diferentes tipos de análisis clínicos.

Para tener acceso a tus resultados, ingresa tu nombre y clave, que se encuentran en la Orden de Atención que se te proporcionó al momento de la toma de muestra.

Como seguridad adicional, el archivo PDF con sus resultados cuenta con una contraseña de acceso. Esta contraseña es su número de Documento de Identidad.
Puedes también escanear desde tu teléfono celular el código QR que se encuentra en tu Orden de Atención para acceder y/o descargar directamente tus resultados.